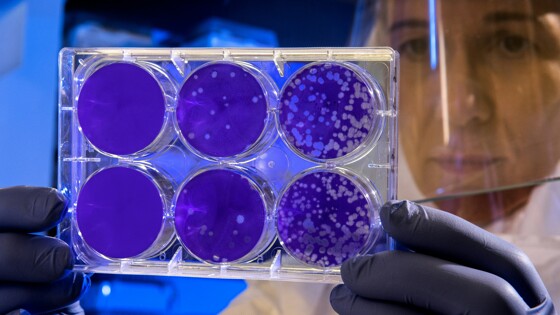

Волгоградский врач предупредила об устойчивости бактерий к антибиотикам
Микробы способны развивать механизмы, которые могут защищать их от воздействия лечебных препаратов. Решение этой проблемы остается одной из важнейших задач медиков современности.
Антибиотики могут не только взаимодействовать с различными структурами бактериальной клетки, но и изменять структуру ее ДНК. Каждый препарат может воздействовать на конкретные бактерии. Поэтому важно использовать только те медикаменты, которые вам назначил врач, отметила главный врач детской поликлиники № 31, главный внештатный детский специалист по профилактической медицине комитета здравоохранения региона Марина Харьковская.
При этом бактерии могут приспосабливаться к неблагоприятным условиям внешней среды, в том числе к воздействию лекарственных препаратов. Чем чаще применяется конкретный антибиотик, тем быстрее микроорганизмы сформируют к нему устойчивость.
Специалисты продолжают искать решение этой проблемы. Однако эволюция бактерий происходит быстрее, чем ученые разрабатывают новые противомикробные препараты. Поэтому для врачей и пациентов важно замедлить развитие антибиотикорезистентности.
Поэтому не стоит принимать антибиотики при лечении вирусных заболеваний. Если врач назначил антимикробный препарат, нужно строго следовать его рекомендациям
Также необходимо принимать меры для профилактики инфекционных заболеваний – избегать переохлаждения, не находиться в местах скопления людей, ограничить контакты с носителями инфекций и не игнорировать иммунизацию. Все это поможет сократить необходимость принимать антибиотики.
Материал носит информационный характер и не заменяет консультации врача.